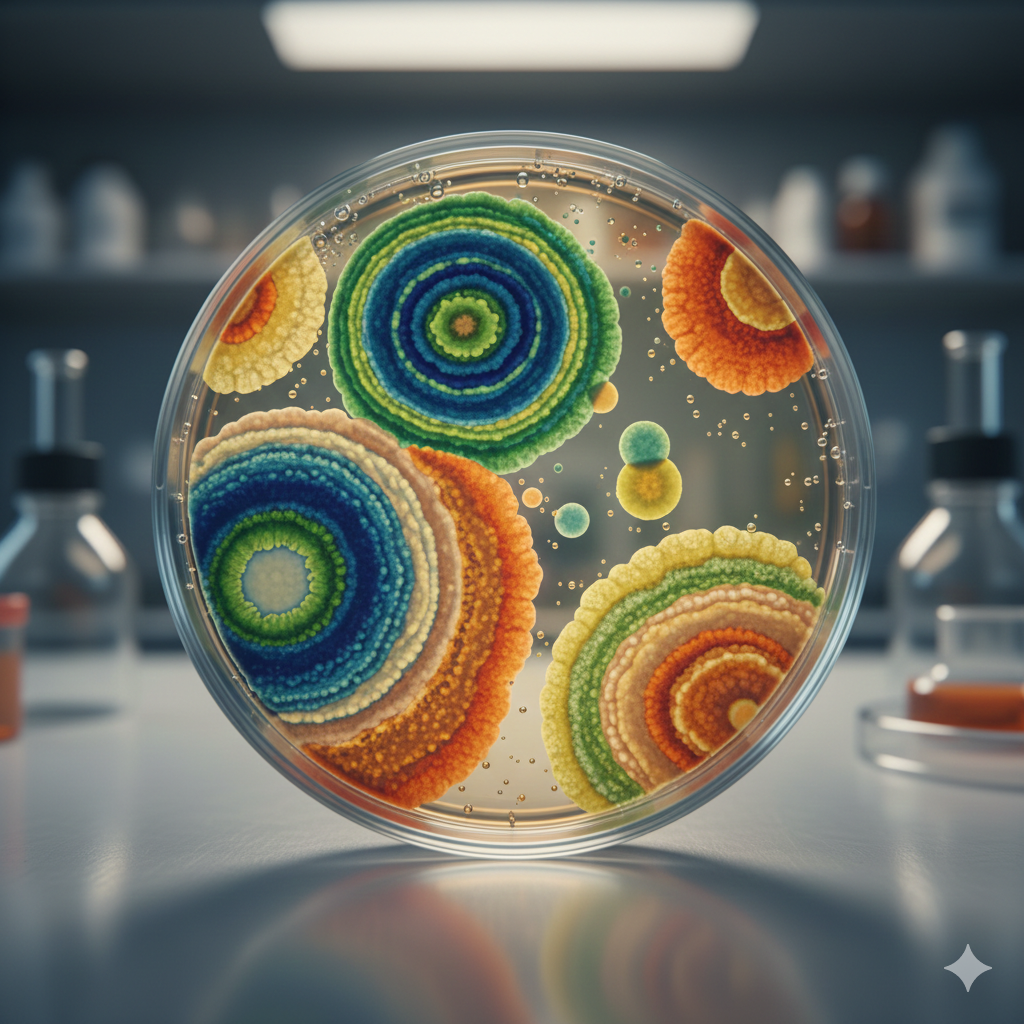

리가켐바이오, 2026년이 진짜 승부처입니다.
4개 핵심 파이프라인의 임상 결과가 올해 줄줄이 발표됩니다. 얀센이 옵션을 행사하면 단번에 2,600억원 현금이 유입됩니다.
증권가에서는 목표주가를 35% 상향 조정하며 '임상 모멘텀의 해'로 평가합니다.
지금부터 리가켐바이오의 2026년 핵심 이벤트와 투자 포인트를 정리합니다.
목차
- 리가켐바이오 기업 개요
- 2026년 핵심 임상 일정
- 주요 파이프라인별 가치 분석
- 기술이전 현황과 기대 수익
- 투자 포인트와 리스크
1. 리가켐바이오 기업 개요
국내 최대 ADC(항체약물접합체) 전문 바이오텍입니다.
자체 개발한 ADC 플랫폼 '컨쥬올(ConjuAll)'을 기반으로 글로벌 제약사에 기술이전하는 비즈니스 모델을 운영합니다. 2024년 오리온그룹에 인수되면서 재정적 안정성도 확보했습니다.
[기업 핵심 지표]
- 상장시장: 코스닥
- 보유 파이프라인: 23개
- 누적 기술이전: 13건, 총 10조원 규모
- 2024년 매출: 1,259억원 (기술이전 수익 중심)
💡 '월드 ADC 어워드'에서 베스트 ADC 플랫폼 부문 7년 연속 수상 기록을 보유하고 있습니다.

2. 2026년 핵심 임상 일정
올해 4개 파이프라인의 임상 결과가 발표됩니다.
미래에셋증권은 2026년을 리가켐바이오의 '임상 모멘텀의 해'로 평가했습니다.
[2026년 주요 이벤트]
상반기
- LCB14(HER2 ADC): 글로벌 임상 1b상 중간 결과 발표
- LCB14: 중국 허가 신청 예상 (복성제약 임상 3상 완료)
- LCB84(Trop2 ADC): 임상 1상 종료 → 얀센 옵션 행사 여부 결정
하반기
- LCB84: 임상 2상 진입 예상
- LCB71(ROR1 ADC): 고형암 임상 1상 데이터 공개 (ASCO)
- LNCB74(B7-H4 ADC): PoC(개념검증) 결과 발표
- LCB39(STING 작용제): 글로벌 임상 1상 개시
⚠️ 임상 결과에 따라 파이프라인이 '기대주'에서 '핵심 자산'으로 격상되거나, 정리 대상이 될 수 있습니다.

3. 주요 파이프라인별 가치 분석
미래에셋증권이 산출한 6개 핵심 파이프라인 가치입니다.
LCB84 (Trop2 ADC) - 신약가치 1조 9,548억원
얀센에 2조 2,400억원 규모로 기술이전된 파이프라인입니다. 국내 단일 파이프라인 역대 최대 계약입니다.
- 적응증: 폐암, 유방암 등 고형암
- 진행 상황: 글로벌 임상 1/2상 진행 중
- 핵심 이벤트: 얀센 옵션 행사 시 2억 달러(약 2,900억원) 수령
경쟁 약물인 길리어드 '트로델비', 아스트라제네카 '다토포타맙'이 비소세포폐암 임상에서 유의미한 결과를 도출하지 못하면서 LCB84의 상대적 가치가 부각되고 있습니다.
LCB14 (HER2 ADC) - 신약가치 1조 4,747억원
리가켐바이오의 첫 ADC 후보물질로, 가장 먼저 상업화될 가능성이 높습니다.
- 적응증: 유방암, 위암, 식도암
- 진행 상황: 중국 임상 3상 완료, 글로벌 임상 1b상 진행 중
- 핵심 이벤트: 2026년 중국 허가 신청 예상
최근 식도암 환자 대상 임상에서 80% 임상적 이점이 확인되었습니다. 엔허투(Enhertu) 내성 환자에서도 64% 반응률을 보여 대안 치료제로서 가능성을 입증했습니다.
LCB71 (ROR1 ADC) - 신약가치 1조 2,302억원
중국 시스톤(CStone)에 기술이전된 파이프라인입니다.
- 적응증: 혈액암, 고형암
- 진행 상황: 글로벌 임상 1b상 환자 등록 중
- 핵심 이벤트: 2026년 ASCO에서 고형암 임상 1상 데이터 공개
전임상 파이프라인 - 합산 가치 2조 8,534억원
LCB97(오노약품 기술이전), LCB02A, LNCB74 등 전임상 단계 파이프라인도 상당한 가치를 인정받고 있습니다.
4. 기술이전 현황과 기대 수익
리가켐바이오는 2019년 이후 매년 1건 이상 기술이전에 성공했습니다.
[주요 기술이전 계약]
- 2023년 12월: 얀센(J&J)에 LCB84 기술이전 - 2조 2,400억원
- 2024년 10월: 오노약품에 LCB97 플랫폼 기술이전 - 약 1조원
- 2020년: 시스톤에 LCB71 기술이전
- 2019년: 익수다에 LCB14, LCB73 기술이전
[2026년 예상 현금 유입]
- 얀센 옵션 행사금: 약 2,900억원 (옵션 행사 시)
- 오노약품 마일스톤: 수령 확정 (금액 비공개)
- 기타 파트너사 마일스톤: 다수 예정
💡 박세진 사장은 JP모건 컨퍼런스에서 "현재 다수의 기술이전 논의가 진행 중"이라고 밝혔습니다.

5. 투자 포인트와 리스크
긍정적 요인
[임상 모멘텀 집중]
2026년 4개 파이프라인의 임상 결과가 연중 발표됩니다. 긍정적 결과 시 기술이전은 자연스럽게 뒤따를 것으로 예상됩니다.
[ADC 시장 환경 유리]
첫 ADC 블록버스터 엔허투 출시 후 기존 페이로드에 대한 내성 문제가 부각되고 있습니다. 리가켐바이오는 다른 작용기전의 페이로드를 보유해 내성 극복 데이터 확보 시 재평가 가능합니다.
[오리온그룹 지원]
인수 후 ADC연구소와 신약연구소를 이원화하고, 머크·루닛 출신 전문가를 영입하는 등 조직을 강화했습니다.
리스크 요인
[임상 실패 가능성]
바이오 기업 특성상 임상 결과가 기대에 못 미칠 경우 주가에 큰 충격이 올 수 있습니다.
[현금흐름 압박]
다수의 임상이 본격화되면서 개발비 지출이 증가하고 있습니다. 2025년 상반기 영업활동현금흐름이 악화된 상태입니다.
[얀센 옵션 미행사 리스크]
LCB84 임상 1상 결과가 기대에 못 미치면 얀센이 옵션을 행사하지 않을 수 있습니다. 이 경우 계약이 종료됩니다.
증권사 의견
- 미래에셋증권: 목표주가 23만원 (35% 상향), 매수
- 하나증권: 목표주가 22만원, 매수
- 한국투자증권: 목표주가 21만원, 매수

마무리
지금까지 리가켐바이오의 2026년 전망을 정리했습니다.
- 올해 4개 핵심 파이프라인 임상 결과 발표 예정
- 얀센 옵션 행사 시 약 2,900억원 현금 유입 가능
- 증권가 목표주가 21~23만원, 전년 대비 대폭 상향
2026년은 리가켐바이오가 '플랫폼 기업'에서 'ADC 에셋 기업'으로 도약하는 원년이 될 수 있습니다. 임상 결과에 주목하세요.
알아두면 좋은 정보:
알테오젠 코스피 이전, 코스닥 바이오 대장주 경쟁 구도 총정리
에이비엘바이오 주가 전망 2026 | 시총 10조 바이오 대장주 분석
에이비엘바이오 그랩바디 플랫폼 뜻 원리 | BBB 셔틀 뇌혈관장벽 쉽게 설명
에이비엘바이오 릴리 기술이전 3.8조 계약 | 계약금 선급금 마일스톤 총정리
에이비엘바이오 ABL001 담도암 FDA 패스트트랙 - 2026 승인 일정 총정리
댓글